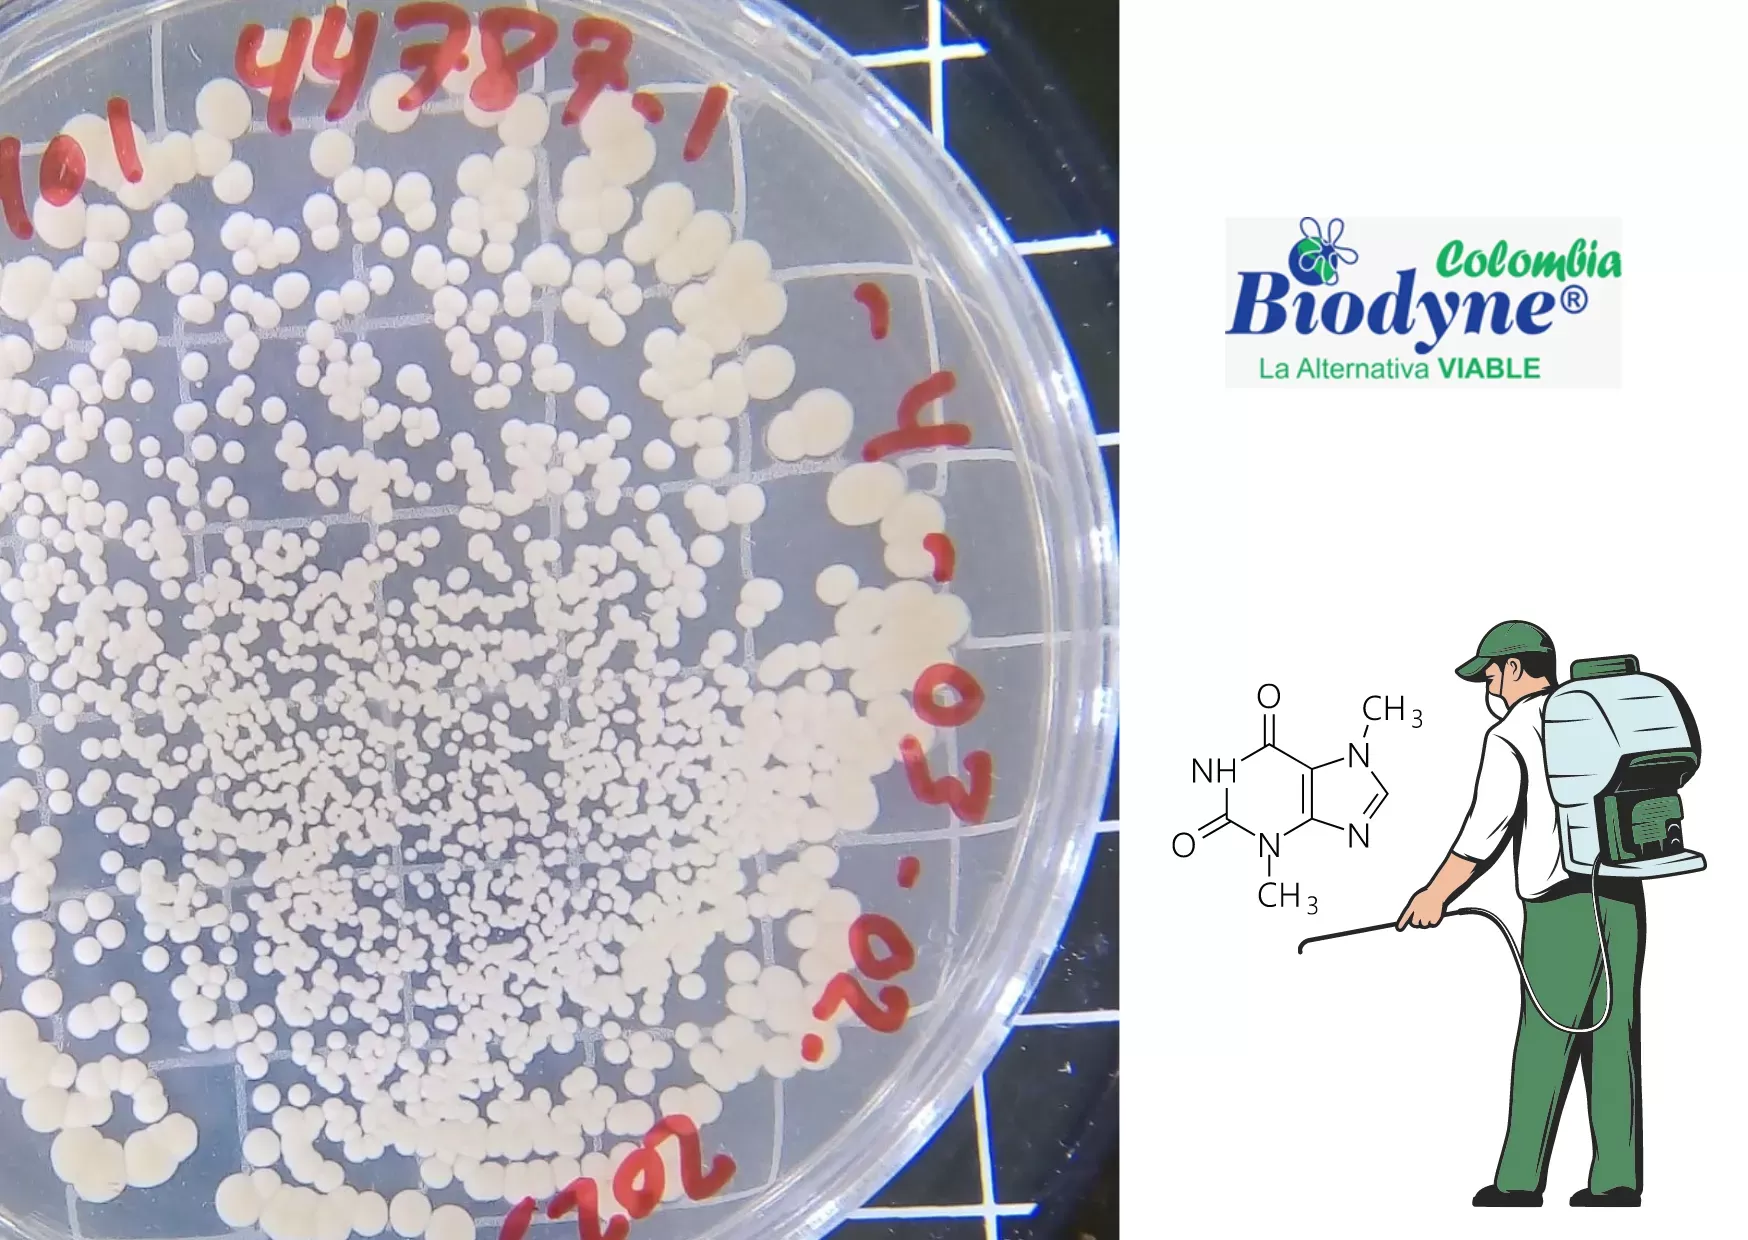

Biodyne® 201 es un consorcio microbiano desarrollado por Biodyne, Inc. en Sarasota, FL, USA a finales de la década de los 90 para tratar suelos y aguas contaminadas por residuos de herbicidas y pesticidas. El inóculo, cuando fue formulado por primera vez, estaba compuesto por 6 cepas de bacterias, pero con el paso de los años y gracias a un intenso programa de investigación y desarrollo, hoy en día cuenta con 27 cepas de bacterias capaces de producir enzimas específicas que pueden degradar muchas de las moléculas que componen estas peligrosas sustancias químicas.
El uso de la biorremediación con Biodyne® 201 para tratar suelos y aguas contaminadas con pesticidas y herbicidas ofrece varios beneficios significativos:
1. Degradación de Contaminantes: Biodyne® 201 puede degradar una amplia variedad de pesticidas y herbicidas, transformándolos en compuestos menos tóxicos o inofensivos. Esto es particularmente efectivo para contaminantes persistentes que pueden durar mucho tiempo en el ambiente si no son tratados adecuadamente.